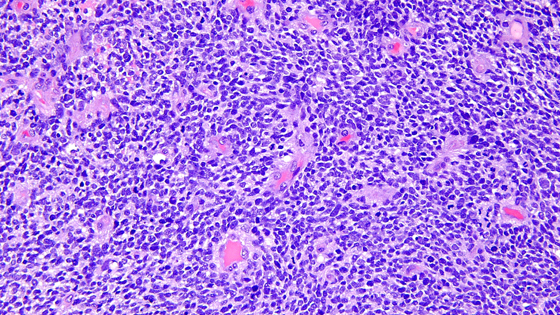
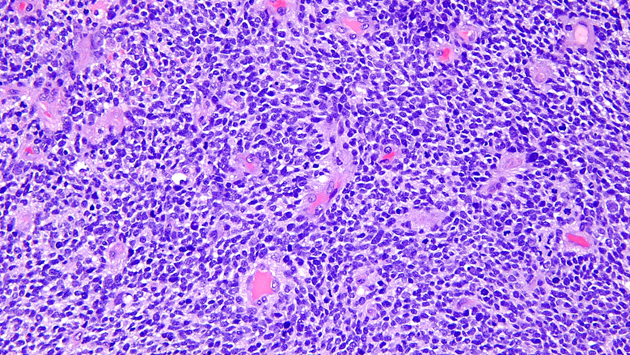

Новый вариант CAR-T-терапии позволил продвинуться в лечении глиобластомы
Новая стратегия лечения рака — терапия химерным рецептором антигена или CAR-T-терапия — стала одной из революций в онкологии. При этом подходе врачи вне тела человека модифицируют собственные иммунные клетки пациента. С его помощью медикам удалось добиться выдающегося прогресса в некоторых нозологиях. Однако в первую очередь речь шла о лимфомах и лейкозах. С солидными (твердыми) опухолями было сложнее. Однако недавно в The New England Journal of Medicine появился отчет о новой модификации метода, который уменьшил одну из самых опасных опухолей головного мозга — глиобластому — у трех пациентов. Хотя полностью избавиться от болезни не получилось — опухоли снова начали расти — сам факт внушает оптимизм, рассказывает портал «Нейроновости».Исследователи из онкологического отделения Массачусетского общего госпиталя и Гарвардского онкологического центра скомбинировали две стратегии лечения — CAR-T и биоспецифические антитела, взаимодействующие с Т-клетками. Новая версия терапии получила название CAR-TEAM и предназначена непосредственно для введения в спинно-мозговую жидкость через желудочек головного мозга.Результаты оказались потрясающими: томограмма показала, что после одной-единственной инъекции модифицированных клеток в желудочек головного мозга уменьшение опухолей было драматически быстрым — всего за несколько дней.Пациенты находились под наблюдением на возникновение токсичности на протяжении всего исследования. Все пациенты получали стандартное лучевое лечение и химиотерапию темозоломидом и были включены в исследование после рецидива заболевания.У 74-летнего мужчины опухоль регрессировала после однократной инфузии новых клеток CAR-TEAM.72-летнему мужчине была проведена однократная инфузия клеток CAR-TEAM. Через два дня после получения клеток МРТ показала уменьшение размера опухоли на 18%. К 69-му дню опухоль уменьшилась на 60%, и реакция сохранялась более шести месяцев.57-летнюю женщину лечили клетками CAR-TEAM. МРТ через пять дней после инфузии показала почти полную регрессию опухоли.Авторы отмечают, что, несмотря на замечательные результаты среди первых трех пациентов, они наблюдали новый рост опухоли во всех случаях, хотя в одном случае прогрессирования не было более шести месяцев.Рост опухоли частично связывают с ограниченной персистенцией клеток CAR-TEAM в течение нескольких недель после инфузии. В качестве следующего шага команда рассматривает возможность серийных инфузий или предварительной подготовки к химиотерапии для продления ответа.«Мы сообщаем о впечатляющем и быстром ответе у этих трех пациентов. Наша работа на сегодняшний день показывает признаки того, что мы добиваемся прогресса, но предстоит сделать еще больше», — говорит соавтор Элизабет Герстнер, нейроонколог общей практики штата Массачусетс.